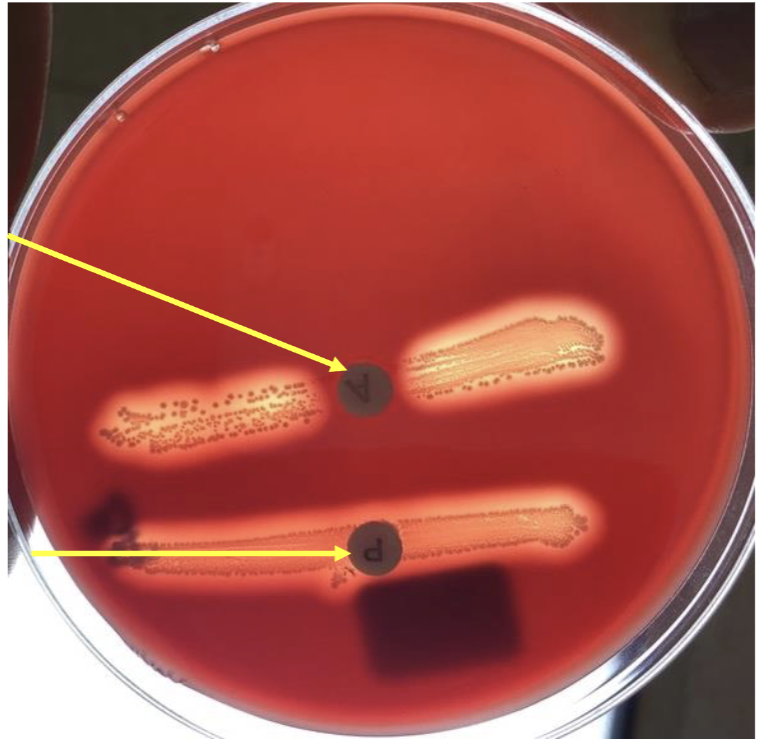
<p>top arrow?</p>
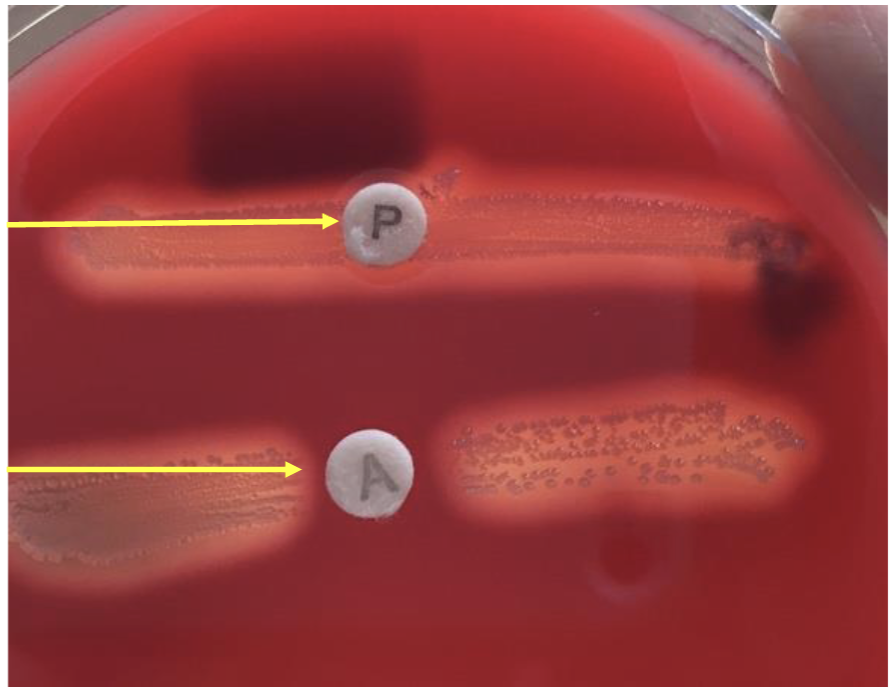
<p>what does yellow line with A mean?</p>
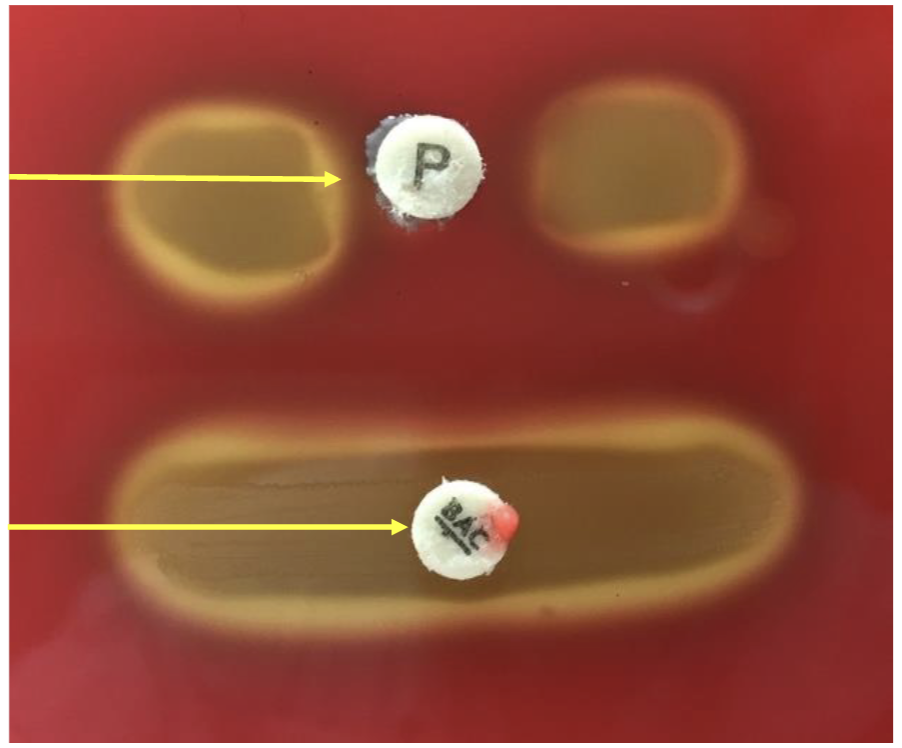
<p>what is the top line with p in it?</p>
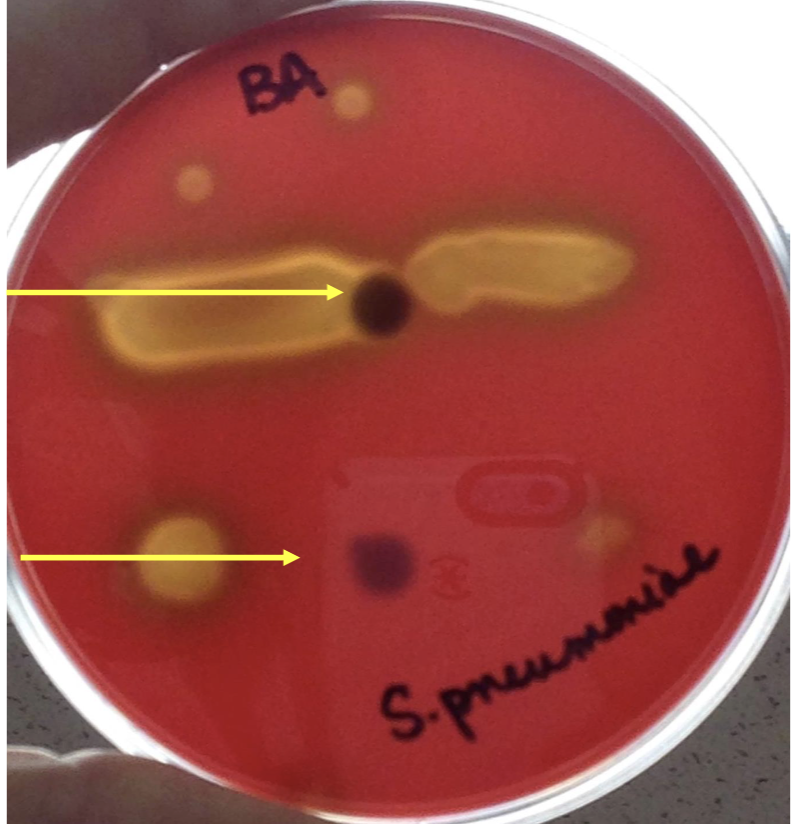
<p>what hemolysis is this?</p>

Streptococcus- Bacitracin, Optochin, BE, Salt,PICTURES MICRO LAB
1/29
There's no tags or description
Looks like no tags are added yet.
Name | Mastery | Learn | Test | Matching | Spaced | Call with Kai |
|---|
No analytics yet
Send a link to your students to track their progress
30 Terms

what’s this?
Streptococcus pyogenes
top arrow?
clearing
sensitive to bacitracin

bottom line?
no clearing
resistant to optochin

what does A disc mean?
bacitracin

what hemolysis is this?
beta hemolysis

what does p disc mean?
optochin

what does this mean?
Streptococcus pyogenes

what hemolysis is this?
beta hemolysis

what is top line with p mean?
no clearing
resistant to optochin
what does yellow line with A mean?
clearing
sensitive to bacitracin

what bacteria?
Streptococcus pneumoniae
what is the top line with p in it?
clearing-
sensitive to
optochin

what is the bottom with bac mean?
no clearing-
resistant to
bacitracin

what does bac mean?
bacitracin

what hemolysis is this?
alpha hemolysis

what bacteria is this?
Streptococcus pneumoniae
what hemolysis is this?
alpha hemolysis

what is the top arrow line?
no clearing-
resistant to
bacitracin

what is the bottom arrow line?
clearing-
sensitive to
optochin

what’s this?
bile esculin

what bacteria and is it + or-?
black positive
Enterococcus faecalis, Streptococcus bovis

what’s this?
6.5% salt broth

whats the left line?
Enterococcus faecalis
turbid- positive;
salt tolerant

whats the right line?
Streptococcus bovis,
Streptococcus pyogenes
not turbid- negative;
not salt tolerant

why is it black?
Black color on slant positive
esculin reaction products react with iron in agar
Black does not indicate H2S production

bile esculin agar- BE- selective agent
bile
selects for bile resistant species

differential agent-bile esculin agar-BE
esculin
esculin hydrolysis
distinguishes bile tolerant species

results for bile esculin
Enterococcus faecalis
black color- positive
grows on bile, uses esculin

Streptococcus bovis-results for bile esculin
black color- positive
grows on bile, uses esculin

results for bile esculin- Streptococcus pyogenes
not black- negative
does not grow on bile